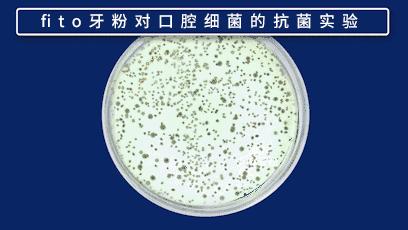
俄罗斯牙膏美白去口臭牙黄,去牙垢黄牙的牙膏测评

有很多妹子和小伙,看上去帅气、靓丽,皮肤白白净净的,但就是死活不愿意露出笑容。到底怎么了?

还不是因为满嘴黄牙!

现在化妆品越来越厉害了,女孩子们都可以用化妆品“变脸”,但却对牙齿黄束手无策。
本来好看的脸蛋,配上一口黄牙,真的大煞风景,形象也有些崩塌。

所以现在的明星、网红都流行去美白牙齿,美白牙齿后的他们真的堪比整容。

究竟是什么东西导致牙黄呢?

比如抽烟的人无论烟瘾多大,100%都有一口老黄牙,焦油和尼古丁吸附在牙齿上,形成黄褐色的烟斑。

而茶和咖啡等饮品都是黄色色素,喜欢喝的朋友,色素逐渐吸附在牙齿表层,形成难以清洗的黄渍。
这是外源性黄牙,长期不清理,也会对牙齿产生腐蚀作用。

除了牙黄,还有嘴里还不断散发出一股难以忍受的恶臭,牙黄、口臭的人也容易出现牙周炎,牙齿松动、脱落是常有的事。

很多人为了挽回一口健康的大白牙,不惜尝试各种方法,花了大把钱不说,效果却不尽人意!
牙贴: 收效甚微,伤害牙釉质
洗牙: 只能去牙垢,不能美白
激光: 副作用大,牙齿发软发酸

美国口腔专家大卫·佩利斯教授说过,想要没有任何口腔问题,最好的途径就是每天坚持刷牙,而其中牙齿清洁产品的重要性占到70%左右!

要是有一款产品,能够简单轻松地美白牙齿,应该是很多人梦寐以求的吧。
不管是多么陈年顽固的老黄牙,只要坚持使用,亮白几个度不在话下。同时还能去除口腔异味,清新口气。

为了美白牙齿,我曾经试过无数种办法:美白牙膏的确可以改善一下牙齿原有的色泽,起到短暂地美白效果,但是效果并不持久,甚至没效果。
可即便如此,倔强的我还是不愿意放弃,屡战屡败,直到我找到了这款洁牙黑科技,俄罗斯的变态发明,号称【口腔清道夫】——fito 菲艾图闪耀烟渍净牙粉 !

fito家牙粉,都经过俄罗斯口腔医学专家研究及测试,通过上千次的临床试验,有显著的口腔清洁力和美白力。
一次刷牙基本=洗牙+冷光美白!压根不是便利店几块、十几块买来的牙膏能比的。

墙裂推荐理由 :
1.优选草本配方,24小时全效白牙
2.高效去黄去渍,给牙齿做清洁spa,7天还你钻石牙
3.抗敏消炎,预防口腔溃疡
4.固齿防蛀,安全不含氟,全家都能用
液态牙粉 快速瓦解牙垢
7天亮白小黄牙
集亮白+护理于一体的洁牙粉,天然成分添加黏土,秒杀所有的大黄牙和口腔异味。
一次见效,快速亮白牙齿,每天提亮牙齿2个色度!不仅牙齿美白了,还改善口腔环境,让你彻底告别大黄牙和口腔异味!

而调和牙粉的是呈膏状的,比普通牙膏要稀一些,不用沾水也能使用且起泡非常的丰富。

味道是薄荷味,每次刷完,舔一圈,牙齿都光溜溜的、特别干净,并且嘴里异味全无,就跟刚刚洗过牙一样!

fito牙粉,作为第一支液态牙粉,能快速洁净口腔牙缝、牙齿表面污垢,口腔的清洁度能达到97%以上。

之所以能有如此高的清洁度,主要是添加的是来自俄罗斯自然保护区的,阿尔泰白粘土。
这种黏土中能提取出一种钙灰成分,具有强大的解析和吸附作用。

纳米级的小颗粒,质地细腻,毫无粗糙和植物颗粒感,能充分地深入牙齿缝隙中。

只需要轻轻一刷,无死角地覆盖齿面上的牙垢污渍,瞬间就没了!
一次就有冷光美牙效果!!

液态牙粉能快速分解并吸附住牙垢,无论是老烟渍,还是咖啡渍的污垢,都能快速清洁干净,恢复钻石牙的闪亮状态!

除垢效果显著,我们用普通的水和fito牙粉水,浸泡两块堆积了水垢玻璃,经过60秒的浸泡。

使用fito牙粉浸泡的玻璃水垢全部消失,就像是一块崭新的玻璃。

而且市面上很多美白牙膏都多少会有侵腐性,用久了会对牙釉质有损伤。
fito采用医学界领先的NOVAMIN修复技术,刷牙时会在牙齿表面形成修复层,有效的保护牙齿~

修复原理就是在你的牙齿套上一层差不多的物质,这层“牙套”还会替牙齿阻挡各种侵蚀和损伤。

这项技术拿到国际专利,还刊登在欧盟极具权威性的临床牙周病学期刊上。

fito清洁能力强悍还能保证零伤害、零腐蚀。

我们做了个小实验,普通牙膏和fito牙粉30秒清洁对比。(蛋壳和牙齿的重要组成同为钙元素)
先在鸡蛋表明用马克笔涂鸦,涂鸦模拟牙垢,普通牙膏和fito牙粉对涂鸦蛋进行30秒清洁。

最后,使用普通牙膏清洁的鸡蛋并未清洁干净,而fito牙粉清洁的干净净,并且蛋壳表面没有任何划痕或被侵蚀痕迹~

普通牙膏 fito牙粉
不仅如此,fito牙粉的zui变态清洁能力,不仅能刷污渍,连同时还不伤害牙齿,简直就是黄牙们的救命牙膏。

各种食品渍、咖啡渍、茶渍等都能慢慢溶解,刷一刷,只需60秒就能祛除陈年牙垢!

我同事让10年烟龄爸爸也尝试了fito牙粉。原本牙齿表面堆积烟渍严重泛黄,洗过几次牙,没过几个月又变黄了。
使用fito牙粉两周后,牙齿越来越白!这哪是刷牙?是做了一次洗牙 + 抛光吧!

fito牙粉形成的一层奶白色的海盐膜,包裹住每一个牙齿,海盐会不断的渗透,持续的淡化顽固性色素。
24小时长效不间断美白!

奶白色的海盐膜会附在表面也会增亮牙齿,从外看上去牙齿又亮又白;每次刷牙3分钟,就能持续美白24小时,并且彻底杜绝了牙齿再变黄的可能。

对于爱吸烟,爱喝咖啡等重色饮料的人来说,fito简直就是美白牙齿的救星。

fito牙粉去牙垢、美白牙齿的效果比洗牙还要好,并且不会伤害到牙齿、牙龈;
更是比洗牙还要彻底、干净,坚持使用,让牙齿从内到外的亮白起来!~

外网上也都是清一色的五星好评: “ 牙齿亮白了”、“口气清新了”、“口腔健康状况也有好转”

清新口气舒爽一天
还能预防口腔溃疡
口腔疾病的罪魁祸首正是细菌,包括葡萄球菌、厌氧链球菌、乳酸杆菌等...这超过700种的细菌,就是口臭的源头。

而在市面上买的牙膏只能杀灭四分之一的细菌,且大多数都含大量的氟对牙齿的健康极其不利。
fito的独家抑菌配方,有效消灭口腔99%以上细菌,能从源头上去口臭!

fito牙粉中的橡树皮、鼠尾草、海盐矿物都是呈弱酸性的,能降低口腔的酸碱环境。

山茶花、洋甘菊、薄荷都有杀菌功效,能全面的抑制、清除口腔内的各种有害细菌。

实验数据显示,fito对致臭细菌、金黄色葡萄球菌、大肠杆菌等的杀菌抑菌率高达99%以上,抑菌效果非常好。
每次刷完牙之后,不仅口腔清凉舒爽,还会伴随着一阵阵的薄荷清香。而且薄荷的清香味可保持在12小时以上。

fito牙粉中就添加了多种养护草本精华,白芷有镇痛、抗炎等作用,人参滋补牙龈,提供牙龈活性,金盏花有利于活血,杏仁则是对损伤的牙龈进行修复。

对于常见的牙龈出血、口腔溃疡以及牙龈肿痛,都有直达根部的缓解功效。

针对经常口腔溃疡的人,还能止痛、修复口腔溃疡;特别是山梨醇还能呵护牙釉质,能预防蛀牙及产生牙菌斑。

我朋友说她,从小牙不好,很容易蛀牙,用过各种牙膏都会刺激敏感,这款fito牙粉像护肤样护理口腔。
滋养口腔软组织,缓解了敏感出血,跑牙科的次数都少了一半!各种冷热酸痛,想吃就吃!

安全不含氟
全家都能用
fito是俄罗斯6大日化企业之一,距今已经55年的历史。
它家优质的产品和显著的效果,在俄罗斯本土很受消费者的喜爱,在俄罗斯、中国、意大利、德国、美国、巴西等20多个国家热销。

fito牙粉是真正健康的洁齿产品,不含氟、防腐剂、化学美白剂等有害成分,完全不会伤害到牙龈、牙齿。

老人、孕妇、小孩也可以放心使用。

闪耀烟渍净牙粉都能有效地消除因吸烟、咖啡、茶,导致的牙齿变黄等症状,让牙齿恢复亮白;
草本清爽牙粉能用草本精华清除口臭,缓解牙龈出血,还你一口健康大白牙!

调和牙粉是管装的,针对不同的口腔问题有6种不同功效,大家可以根据自己的需求来做选择啦,焕白3天效果能看到~

全是俄罗斯原装进口,经过国家进出口检疫局检疫,海关报税单等证件齐全,安全和质量都有保证!

用过的朋友效果明显看得见!什么黄牙、烟渍牙、茶渍牙、氟斑牙,通通没有了!涂上口红更加显白了!

呼出的口气还有种淡淡的,薄荷清香味~笑起来的一口大白牙,口气清新又好闻,对象恨不得马上抱住你亲你一口。

一口健康的大白牙,搭配上清新宜人的口气,气场颜值马上提升一个level!
让俄罗斯fito牙粉,给牙齿来个美白养生SPA吧!
现在购买
可享受 团购优惠 !
▼

商务合作
微信ID:TrendsZaijia006
微信ID:TrendsZaijia010
后台回复“转载”,获取转载须知